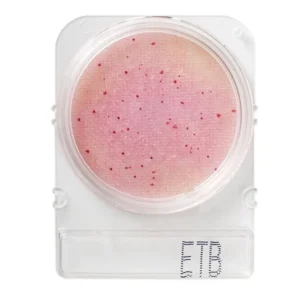
Teste Rápido Microbiológico Compact Dry Enterobactérias Etb

Menu
Institucional
Prlabor – Retire seu pedido 2 dias úteis após a sua compra. Rua Pio XII, 573, Neva, Cascavel/PR – Atendimento de Segunda à Sexta das 08:00 às 12:00 e 13h30 às 17:45.
Em casos específicos (produtos com temperatura controlada, equipamentos, etc) realizamos comparações de prazo de entrega por correio e transportadoras e tomamos a liberdade de despachar pelo Frete mais rápido e/ou seguro.
Teste Rápido Microbiológico Compact Dry Bactérias Totais TC
Compact Dry são placas prontas para detecção e quantificação microbiológicas em matérias-primas, alimentos e ambiente. É um método de ensaio microbiológico pronto para uso que permite uma perfeita absorção das amostras inoculadas. Permite quantificar a maioria das bactérias de interesse para a indústria alimentícia.
Maior agilidade e praticidade para análises;
Pronto para uso: aumento da capacidade analítica do laboratório;
Redução de materiais auxiliares e desperdícios;
Redução de 90% do espaço ocupado para estocagem e incubação;
Redução de erro analítico;
Resultados rápidos e precisos;
Apenas 3 passos: inoculação, incubação e leitura;
Esterilizadas individualmente; tecnologia da Alemanha.
Características:
Temperatura para armazenamento: Ambiente
Aplicação: Bactérias Totais
Incubação: 48 horas
Temperatura: 35 ± 2°C
Validação (Ref.No.) | MicroVal: RQA2007LR01
Validação (Ref.No.) | NordVal: 033
Validação (Ref.No.) | AOAC-RI: 010404
Imagens Meramente Ilustrativas